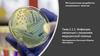
Инфекции, связанные с оказанием медицинской помощи. Тема 2.1.1

Похожие презентации:
Обеззараживание рук медицинских работников и кожных покровов пациентов при оказании медицинской помощи
1. "МУ 3.5.1.3674-20. 3.5.1. Дезинфектология. Обеззараживание рук медицинских работников и кожных покровов пациентов при оказании
"МУ 3.5.1.3674-20. 3.5.1.Дезинфектология.
Обеззараживание рук медицинских
работников и кожных покровов
пациентов при оказании медицинской
помощи.
Методические указания"
(утв. Главным государственным
санитарным врачом РФ 14.12.2020)
Гл. медсестра
ЖОГОЛЕВА В.В.
2.
ГОСУДАРСТВЕННОЕ САНИТАРНОЭПИДЕМИОЛОГИЧЕСКОЕ НОРМИРОВАНИЕРОССИЙСКОЙ ФЕДЕРАЦИИ
I. Область применения
1.1.Настоящие методические указания (далее
- МУ) содержат общие рекомендации по выбору и
применению кожных антисептиков и направлены
на снижение риска возникновения инфекций,
связанных с оказанием медицинской помощи
(далее - ИСМП), у пациентов, а также
профессиональных
заболеваний
работников
медицинских организаций.
3.
II. Область применения2.1.
В
медицинских
организациях
главным
фактором
передачи
возбудителей
ИСМП
от
пациентов - медицинским работникам и от
медицинских работников - пациентам являются
руки медицинских работников.
2.2. Для обеззараживания кожи рук персонала
медицинских организаций, посетителей, кожных
покровов
пациентов
применяют
кожные
антисептики
химические
дезинфицирующие
средства, обладающие антимикробной активностью
и обеспечивающие уничтожение транзиторной
и/или
снижение
до
безопасного
уровня
резидентной микрофлоры, характеристика которой
представлена в приложении 1 к настоящим МУ.
4.
2.3.Использование
кожных
антисептиков
в
медицинских
организациях
осуществляется
в
соответствии
с
санитарно-эпидемиологическими
требованиями <1>.
-------------------------------<1>
СанПиН
2.1.3.2630-10
"Санитарноэпидемиологические
требования
к
организациям,
осуществляющим
медицинскую
деятельность",
утвержденные
постановлением
Главного
государственного
санитарного
врача
Российской
Федерации от 18.05.2010 N 58 (зарегистрировано
Минюстом России 09.08.2010, регистрационный N
18094), с изменениями, внесенными постановлениями
Главного
государственного
санитарного
врача
Российской
Федерации
от
04.03.2016
N
27
(зарегистрировано
Минюстом
России
15.03.2016,
регистрационный N 41424), от 10.06.2016 N 76
(зарегистрировано
Минюстом
России
22.06.2016,
регистрационный N 42606).
5.
2.4. По назначению кожные антисептики делятся наследующие классы:
- класс А - для обработки кожи операционного и
инъекционного полей пациентов;
- класс Б - для обработки рук хирургов и других
медицинских работников, участвующих в выполнении
оперативных и иных инвазивных вмешательств;
- класс В - для гигиенической обработки кожных покровов.
2.5.
В
медицинской
организации
необходимо
использовать кожные антисептики в соответствии с
предназначением (областью применения), имеющие
свидетельство о государственной регистрации <2>,
декларацию о соответствии <3>, инструкцию по
применению, этикетку.
2.6. Не рекомендуется использование антисептиков в
форме
спрея
в
непосредственной
близости
с
новорожденным ребенком.
6.
III. Кожные антисептики класса А3.1. Кожные антисептики класса А предназначены для
обработки кожи операционного поля, кожи локтевых сгибов
доноров, кожи мест введения/входа пункционной иглы или
установки катетера, включая использование стерильных
систем для переливания крови и других жидкостей, а также
кожи инъекционного поля.
Указанные области применения
предусматриваются инструкцией
по применению кожного антисептика.
3.2. Кожные антисептики класса А
обеспечивают снижение общей микробной
обсемененности поверхности кожи не
менее чем на 100%, за исключением
кожных антисептиков, предназначенных
для обработки кожи инъекционного поля, которые
обеспечивают снижение общей микробной обсемененности
не менее, чем на 95%.
7.
3.3. При использовании кожных антисептиков классаА обработку кожи операционного поля, кожи мест
введения/входа пункционной иглы или установки
периферического/центрального венозного катетера
проводят только способом протирания двукратно,
последовательно,
отдельными
стерильными
салфетками/тампонами,
смоченными
кожным
антисептиком. Кожу инъекционного поля протирают
однократно стерильными салфетками/тампонами или
орошают кожным антисептиком из флакона с
распылителем
или
используют
готовые
к
использованию
салфетки,
пропитанные
кожным
антисептиком.
Необходимое для обработки количество кожного
антисептика и время его экспозиции определяются
инструкцией по применению конкретного препарата.
После обработки необходимо выдержать интервал не
менее 30 секунд для высыхания поверхности кожных
покровов.
8.
3.4. Для детей в возрасте до 7 летрекомендуется применять кожные антисептики
класса А на основе этилового спирта без
добавления других действующих веществ. Для
кожи новорожденных с массой тела более 1500
г применяют спирт этиловый 70%. Для
обработки кожи новорожденных с массой тела
менее 1500 г применяют предназначенные для
них антисептические лекарственные средства,
которые после применения необходимо смыть
стерильной салфеткой, пропитанной водой для
инъекций.
3.5.
Для
обработки
операционного
поля
предпочтительнее
применять
кожные
антисептики класса А с красителем для
визуального
определения
границы
обработанного участка.
9. IV. Кожные антисептики класса Б
4.1. Кожные антисептики класса Бпредназначены для обработки рук
специалистов, участвующих
в выполнении оперативных
и иных инвазивных вмешательств.
Указанная область применения
предусматривается инструкцией по
применению кожного антисептика.
4.2. Кожные антисептики класса Б
обеспечивают снижение общей микробной
обсемененности поверхности кожи не
менее, чем на 100%.
10.
4.3. Обработку рук кожным антисептиком класса Бпроводят перед выполнением любых оперативных
вмешательств или других инвазивных процедур,
манипуляций
любой
локализации,
продолжительности, сложности, в т.ч.:
- перед катетеризацией магистральных сосудов;
- перед установкой/заменой инвазивного/дренажного
устройства;
- перед пункциями тканей, полостей, сосудов,
спинномозговых каналов;
- перед выполнением стерильных эндоскопических
манипуляций;
- перед приемом родов;
при
проведении
процедур
и
уходе
за
новорожденными
в
отделениях/палатах
реанимации
и
интенсивной
терапии
для
новорожденных.
11.
4.4. До нанесения кожного антисептика кисти рук,запястья и предплечья до локтей включительно моют
в течение двух минут без применения щеток теплой
проточной водой с жидким мылом без антимикробных
компонентов. Затем руки высушивают (промокают)
одноразовой стерильной тканевой салфеткой или
стерильным полотенцем.
Следуя определенному алгоритму (приложение
3 к настоящим МУ), кожным антисептиком класса Б
обрабатывают кисти рук, запястья и предплечья до
локтей включительно. Кожный антисептик наносят
отдельными порциями, равномерно распределяют и
тщательно втирают в кожу, поддерживая руки во
влажном состоянии в течение времени обработки.
Количество кожного антисептика на одну обработку,
кратность обработки и ее продолжительность должны
соответствовать
инструкции
по
применению
препарата.
12. V. Кожные антисептики класса В
5.1. Кожные антисептики класса В предназначены длягигиенической обработки рук работников медицинских и др.
организаций на всех этапах оказания медицинской помощи, а
также ее обеспечения, включая работников пищеблоков и
других
вспомогательных
подразделений;
лиц,
осуществляющих
уборку
помещений,
обслуживание
оборудования, другие работы в помещениях, предназначенных
для оказания медицинской помощи, а также для пациентов,
членов их семей, других лиц при посещении пациентов и
уходе за ними.
Возможность
использования
кожного
антисептика
для
гигиенической обработки рук предусматривается инструкцией
по его применению.
5.2. Кожные антисептики класса В обеспечивают снижение
общей микробной обсемененности поверхности кожи не менее,
чем на 95%.
13.
5.3. Обработку рук кожным антисептиком класса В(приложение 4 к настоящим МУ) проводят:
- до и после непосредственного контакта с
пациентом;
- после контакта с биологическими жидкостями,
секретами или экскретами организма, слизистыми
оболочками, повязками;
- перед выполнением инвазивных процедур (до
контакта с инвазивным оборудованием и изделиями),
кроме перечисленных в п. 4.3;
- после контакта с медицинским оборудованием и
другими объектами, находящимися в непосредственной
близости от пациента;
- при переходе от более контаминированного
микроорганизмами участка тела пациента к менее
контаминированному
при
оказании
медицинской
помощи и уходе за пациентом;
- после снятия медицинских перчаток.
14. VI. Гигиена рук медицинского персонала
6.1.Для
обеспечения
эффективного
мытья
и
обеззараживания
рук
необходимо
соблюдать
следующие условия:
- ногти на руках - чистые, коротко остриженные, не
покрытые лаком;
- отсутствие искусственных ногтей;
- на пальцах и кистях рук - отсутствие колец,
перстней, элементов пирсинга, других украшений;
перед обработкой рук хирургов необходимо снять
часы, браслеты, другие украшения рук и предплечий;
- микротравмы (порезы, проколы, заусеницы,
царапины, микротрещины) необходимо обработать
антисептическим лекарственным средством и закрыть
водостойким лейкопластырем.
15.
6.2. Мытье рук жидким мылом и водой необходимопри их явном загрязнении, при этом следует
соблюдать
определенную
последовательность
(приложение 5 к настоящим МУ).
6.3. Мытье рук мылом не является заменой обработки
рук кожным антисептиком.
6.4. После мытья руки высушивают, промокая их
салфеткой/полотенцем однократного использования;
не следует применять электросушители. Салфетки
(полотенца) бумажные однократного применения
выбирают
с
достаточной
гигроскопичностью,
плотностью, не оставляющие после использования
видимых волокон на коже рук. Не следует надевать
перчатки на влажные руки.
16.
6.5.Необходимо
обеспечить
доступность
кожных
антисептиков, предназначенных для гигиенической обработки
рук, в достаточном количестве для всех пользователей. Для
этого
дозаторы
(диспенсеры)
кожных
антисептиков
размещают в наиболее востребованных местах, удобных для
применения персоналом, пациентами, посетителями - у входа
(выхода)
в
отделение,
процедурную,
перевязочную,
манипуляционную, палату, бокс, туалет и др. (приложение 6 к
настоящим МУ), обеспечивая их бесперебойную работу. Для
отдельных категорий персонала, связанного с частым
посещением отделений и палат в дополнение к дозаторам
целесообразно
использовать
кожные
антисептики
в
индивидуальных
флаконах
небольшого
(100
200
миллилитров) объема.
6.6. Для ухода за кожей рук перед рабочей сменой, перед
обеденным перерывом и после него, а также в конце рабочей
смены
рекомендуется
использовать
смягчающие
и
увлажняющие, питающие кожу кремы, лосьоны, бальзамы.
17. VII. Санитарная обработка антисептиками кожных покровов пациентов
7.1. Санитарная обработка антисептиками кожных покрововпациентов (полная или частичная) предназначена для
удаления загрязнений и снижения количества транзиторной
микрофлоры, проводится по показаниям и не заменяет
гигиенические процедуры (мытье водой с мылом).
7.2. Санитарную обработку кожных покровов проводят при
поступлении
в
отделение,
накануне
оперативного
вмешательства или при уходе за пациентом.
7.3. Для санитарной обработки кожных покровов используют
кожные антисептики класса В, не содержащие спиртов,
обладающие моющими свойствами.
7.4. Всю поверхность тела, либо отдельный участок кожи
протирают/моют салфеткой или тампоном, смоченным кожным
антисептиком либо готовой к применению салфеткой,
пропитанной кожным антисептиком.
18. VIII. Организация мероприятий по обеспечению эффективного обеззараживания рук и формированию приверженности медицинского
персонала гигиене рук обеспечиваетадминистрация организации
8.3. Мероприятия по обеспечению эффективного
обеззараживания рук включают:
организационное
обеспечение
мероприятий:
разработка и утверждение инструкций; назначение лиц,
ответственных за реализацию мероприятий и контроль
их
исполнения;
мониторинг
эпидемиологической
ситуации, выполнения методики обеззараживания рук;
расчет необходимого количества кожных антисептиков и
учет их расхода;
19.
систематическоеобучение
пациентов,
посетителей
правилам
обработки
рук,
использование всех доступных средств наглядной
информации о необходимости обработки рук,
правилах ее проведения;
систематическое
обучение
медицинского
персонала правилам обработки рук при поступлении
на работу и далее не менее 1 раза в год, и
дополнительно при внесении изменений в схему
обработки рук (смена оборудования, дозаторов и
др.),
а
также
с
учетом
результатов
производственного контроля;
постоянный
контроль,
включая
микробиологический, за соблюдением методики
обеззараживания рук, разработка и реализация мер
реагирования на выявленные нарушения.
20. МИКРОФЛОРА РУК МЕДИЦИНСКИХ РАБОТНИКОВ И КОЖНЫХ ПОКРОВОВ ПАЦИЕНТОВ
Микроорганизмы,обитающие
на
коже
рук
медицинских
работников
и
контаминирующие
кожные
покровы
пациентов,
представлены
резидентной
(естественной,
постоянной)
и
транзиторной
(временно
присутствующей)
микрофлорой.
Наибольшее
эпидемиологическое
значение имеет транзиторная микрофлора.
Микроорганизмы,
представляющие резидентную
микрофлору, постоянно обитают на коже. В основном
они находятся в глубоких слоях кожи, в том числе в
сальных и потовых железах, волосяных фолликулах.
21.
3.Резидентнаямикрофлора
не
вызывает
патологических процессов на неповрежденной коже,
однако может стать причиной инфекционного процесса
при попадании в стерильные полости организма
человека либо на поврежденную кожу. Резидентные
микроорганизмы невозможно удалить полностью, однако
можно снизить их количество применением кожных
антисептиков.
4.
Транзиторная микрофлора попадает на руки
медицинского персонала при контакте с пациентами и
проведении различных диагностических и лечебных
вмешательств,
а
также
при
контакте
с
контаминированными
объектами
внутрибольничной
среды и может длительно выживать на коже.
Транзиторная микрофлора может быть представлена
патогенными и условно-патогенными микроорганизмами,
имеющими различную степень эпидемиологической
опасности для пациентов и медицинских работников.
22.
Средиграмположительных
микроорганизмов
наибольшее значение имеют Staphylococcus aureus, в
том
числе
метициллин-резистентный
золотистый
стафилококк (MRSA), Streptococcus spp, Mycobacterium
tuberculosis.
Среди
грамотрицательных
микроорганизмов
возбудителями
ИСМП
могут
быть
Pseudomonas
aeruginosa, Acinetobacter baumannii, Klebsiella spp. (в
частности, Klebsiella pneumoniae), Enterococcus spp., в
том числе ванкомицин-резистентный энтерококк (VRE),
Salmonella spp., а также Clostridium difficile - возбудитель
псевдомембранозного энтероколита.
Перечисленные в данном пункте возбудители ИСМП и
другие возможные возбудители ИСМП (например,
вирусы парентеральных гепатитов, ВИЧ, герпеса,
цитомегалии, грибы рода Candida и т.д.) могут
передаваться
через
необеззараженные
руки
медицинского персонала и пациентов.
23.
5. Факторами, определяющими вероятность контаминациирук
транзиторной
микрофлорой
и
распространения
возбудителей ИСМП, является наличие источников инфекции
среди пациентов и медицинского персонала, виды и частота
применяемых
инструментальных
методов
обследования,
диагностики и лечения больных, тип используемой лечебной и
диагностической
аппаратуры,
количество
проводимых
инвазивных диагностических и лечебных процедур.
Обеззараживание
антисептиками
рук
медицинских
работников и кожных покровов пациентов необходимо
выполнять во всех случаях, когда имеется реальная или
потенциальная вероятность контаминации микроорганизмами
на всех этапах оказания медицинской помощи и ухода за
пациентами.
Показателями качественной гигиенической обработки рук
служит отсутствие в смывах с рук санитарно-показательных
микроорганизмов, вегетативных форм патогенных и условнопатогенных микроорганизмов, а после обработки рук хирургов
- отсутствие любых видов микроорганизмов в смывах с рук.
24. ФОРМЫ, ВИДЫ И ХАРАКТЕРИСТИКИ КОЖНЫХ АНТИСЕПТИКОВ
1. Кожные антисептики выпускают в виде готовых кприменению спиртовых или водных растворов, гелей,
дезинфицирующих
салфеток,
жидких/пенных
мыл
с
антимикробными свойствами (кожные антисептики - моющие
средства). Способ обработки рук зависит от формы выпуска
антисептика. Растворы, гели втирают в кожу, нанося средство
из флакона, дозатора; дезинфицирующими салфетками
протирают кожу рук; кожными антисептиками-моющими
средствами моют кожные покровы. Количество антисептика и
время обработки определяется инструкцией по применению
препарата.
Действующими веществами кожных антисептиков являются
спирты (этиловый (этанол), изопропиловый (пропанол-2),
пропиловый (пропанол-1) или смеси этих спиртов в разных
количественных соотношениях), а также действующие
вещества из других групп химических соединений.
25.
2.Спиртосодержащие
(без
дополнительных
антимикробных добавок) кожные антисептики имеют, как
правило, оптимальную эффективность при концентрации
спиртов (по массе): этилового - не менее 70%,
изопропилового - не менее 60%, пропилового - не менее
50%; в композиционных составах кожных антисептиков
оптимальное суммарное содержание этилового и/или
изопропилового
и/или
пропилового
спиртов
должно
составлять 60 - 70%.
3. Кожные антисептики должны отвечать следующим
характеристикам:
- короткое время обработки;
необходимый
(в
соответствии
с
назначением
антисептика)
спектр
антимикробного
действия,
обеспечивающий
гибель
грамположительных
и
грамотрицательных бактерий, патогенных грибов, вирусов,
других возбудителей ИСМП;
- безопасность для персонала и пациентов;
- удобная для применения форма выпуска.
26. АЛГОРИТМ ОБРАБОТКИ РУК ХИРУРГОВ КОЖНЫМ АНТИСЕПТИКОМ <4>
АЛГОРИТМ ОБРАБОТКИ РУК ХИРУРГОВ КОЖНЫМАНТИСЕПТИКОМ <4>
<4> Необходимое количество антисептика и продолжительность
обработки определяется инструкцией по применению средства.
27.
I. Алгоритм обработки рук хирургов кожнымантисептиком:
1) нанести примерно 5 мл (2 - 3 дозы) спиртосодержащего
средства в ладонь левой руки, используя локоть правой руки
для управления дозатором (рис. 1);
2) погрузить в средство кончики пальцев правой руки для
обеззараживания подногтевых пространств (рис. 2);
3) распределить средство по всей поверхности правого
предплечья круговыми движениями до высыхания средства
(10 - 15 секунд) (рис. 3 - 7);
4) нанести примерно 5 мл (2 - 3 дозы) спиртосодержащего
средства в ладонь правой руки, используя локоть левой руки
для управления дозатором (рис. 8);
5) погрузить в средство кончики пальцев левой руки для
обеззараживания подногтевых пространств (рис. 9);
6) распределить средство по всей поверхности левого
предплечья круговыми движениями до высыхания средства
(10 - 15 секунд) (рис. 10);
28.
7) нанести примерно 5 мл (2 - 3 дозы) спиртосодержащегосредства в ладонь левой руки, используя локоть правой руки
для управления диспенсером (рис. 11). Обработать руки до
запястья в соответствии с рисунками 12 - 16 в течение 20 - 30
секунд:
- нанести средство на всю поверхность кистей рук до запястья и
круговыми движениями растереть средство (рис. 12);
- обработать тыльную сторону левой руки, включая запястье,
двигая правую ладонь вперед-назад; поменять руки и
выполнить процедуру для другой руки (рис. 13);
- переплести пальцы и растереть ладонью ладонь (рис. 14);
- соединить пальцы в "замок", тыльной стороной согнутых
пальцев левой руки растирать ладонь правой руки движениями
вперед и назад; поменять руки и выполнить процедуру для
другой руки (рис. 15);
- охватить большой палец левой руки правой ладонью и потереть
его круговыми движениями; поменять руки и выполнить
процедуру для другой руки (рис. 16);
8) когда антисептик высохнет, надеть стерильные перчатки
(рис. 17).
Примечание: приведена схема обработки рук для праворуких
людей (правшей).
29. АЛГОРИТМ ГИГИЕНИЧЕСКОЙ ОБРАБОТКИ РУК КОЖНЫМ АНТИСЕПТИКОМ <5> <5> Необходимое количество антисептика и продолжительность
АЛГОРИТМГИГИЕНИЧЕСКОЙ ОБРАБОТКИ РУК КОЖНЫМ
АНТИСЕПТИКОМ <5>
<5> Необходимое количество антисептика и продолжительность
обработки определяется инструкцией по применению средства.
30.
1. Алгоритм обработки рук кожным антисептиком:1) нанести антисептик на ладонь (рис. 1a, 1b);
2) потереть одну ладонь о другую (рис. 2);
3) правой ладонью растереть антисептик по тыльной
поверхности левой кисти, переплетая пальцы, и наоборот
(рис. 3);
4) переплести пальцы, растирая ладонь о ладонь (рис. 4);
5) соединить пальцы в "замок", тыльной стороной согнутых
пальцев растирать ладонь другой руки (рис. 5);
6) охватить большой палец левой руки правой ладонью и
потереть его круговыми движениями, поменять руки и
выполнить процедуру для другой руки (рис. 6);
7) круговыми движениями в направлении вперед и назад
сомкнутыми пальцами правой руки потереть левую ладонь,
поменять руки и выполнить процедуру для другой руки (рис.
7);
8) когда антисептик высохнет, надеть перчатки. Руки готовы к
работе (рис. 8).
Примечание: приведена схема обработки рук для праворуких
людей (правшей).
31. АЛГОРИТМ МЫТЬЯ РУК МЫЛОМ И ВОДОЙ
32.
1. Алгоритм мытья рук мылом и водой:1) увлажнить руки водой (рис. 1);
2) нанести на ладони необходимое количество мыла
(рис. 2);
3) потереть одну ладонь о другую (рис. 3);
4) правой ладонью растереть мыло по тыльной
поверхности левой кисти и наоборот (рис. 4);
5) переплести пальцы, растирая ладонь о ладонь (рис.
5);
6) соединить пальцы в "замок", тыльной стороной
пальцев растирать ладонь другой руки (рис. 6);
7) охватить большой палец левой руки правой
ладонью и потереть его круговыми движениями,
поменять руки (рис. 7);
33.
8) круговыми движениями в направлении вперед иназад сомкнутыми пальцами правой руки потереть
левую ладонь, поменять руки (рис. 8);
9) тщательно смыть мыло под проточной
водопроводной водой (рис. 9);
10) тщательно промокнуть одноразовым полотенцем
(салфеткой) (рис. 10);
11) использовать полотенце для закрытия крана (рис.
11);
12) руки готовы к работе (рис. 12).
Примечание: приведена схема обработки рук для
праворуких людей (правшей).
34. ИСПОЛЬЗОВАНИЕ ДОЗАТОРОВ
1. Дозаторы представляют собой устройства длядозированного
нанесения
кожного
антисептика
или
жидкого/пенного мыла на руки. Для безопасного хранения
и
удобного
дозированного
извлечения
расходных
материалов (полотенец, перчаток, салфеток и др.) также
используют специальные дозаторы (диспенсеры).
Применение механических или сенсорных дозаторов
снижает риск перекрестной контаминации рук медицинских
работников, пациентов, исключая или сводя к минимуму,
контакт обрабатываемой кожи рук с устройством для
дозирования, позволяет регулировать количество средства.
2. При использовании дозатора с заливным флаконом
новую порцию антисептика (или мыла) наливают в дозатор
после его опорожнения с последующими дезинфекцией,
промыванием водой и высушиванием (всех частей
дозатора). Дозаторы одноразового применения, повторному
использованию не подлежат (доливать новую порцию
антисептика или мыла в используемый дозатор с остатками
средства не допускается!).
35.
3. Разнообразные модели сенсорных дозаторов могутработать от сети, батареек, или от обоих источников
питания.
Выпускаются
также
автоматические
системы/станции, позволяющие дозированно наносить
на руки антисептики, жидкое мыло и воду. Полная
автоматизация
работы
устройства,
возможность
настройки режимов дозирования снижают общий расход
кожных антисептиков. Существуют модели дозаторов
кожных антисептиков, подключаемые к автоматическим
дверям. При этом двери откроются только в случае
использования дозатора, что позволяет применять их
при
входе
(выходе)
в
помещения
высокого
эпидемиологического риска - отделения интенсивной
терапии, ожоговые, родильные, инфекционные и т.п.
4.
Некоторые модели дозаторов имеют цветовое
кодирование. Рекомендуется использовать разные цвета
дозаторов в разных зонах медицинской организации в
зависимости
от
требований
к
санитарнопротивоэпидемическому режиму конкретной зоны.
36.
5. Дозаторы с кожными антисептиками должны бытьмаксимально доступны. Их размещают при входе в
отделения,
палаты,
кабинеты,
туалеты,
другие
помещения высокого эпидемиологического риска; в
отделениях с высокой интенсивностью ухода за
пациентами - у постели больного.
Диспенсеры для мыла и салфеток должны находиться в
непосредственной близости от раковин, на расстоянии
не более 40 см от смесителя (справа, слева или сверху).





































 Медицина
Медицина